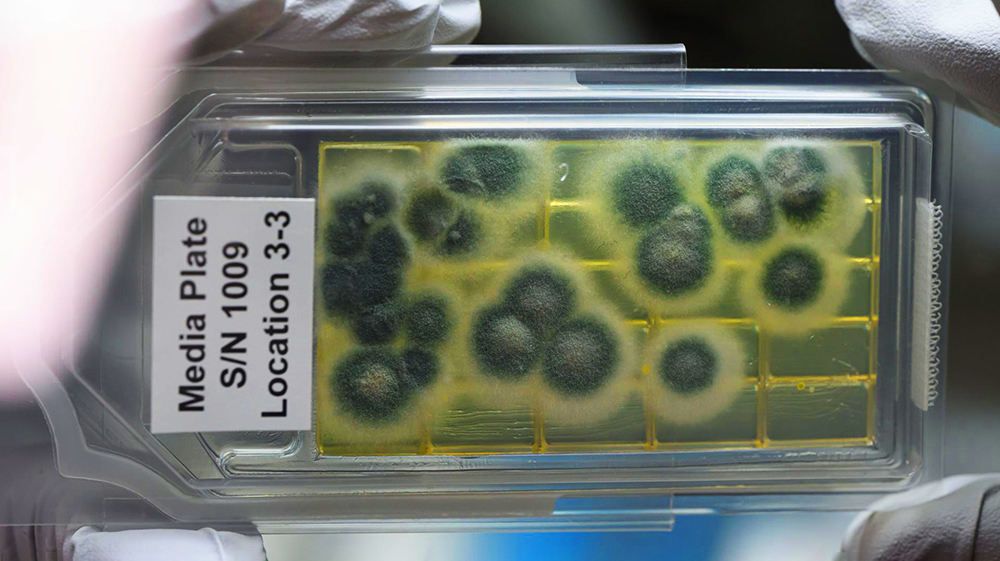

Бактерия из стерильных зон НАСА «притворяется мертвой», чтобы выжить
Найденный в неожиданной среде микроорганизм умеет скрываться от обнаружения, «притворяясь мертвым».
Бактерия Tersicoccus phoenicis была обнаружена в чистых помещениях НАСА во Флориде и Французской Гвиане более 10 лет назад. Открытие удивило ученых, поскольку сборочные цеха подвергаются тщательной дезинфекции во избежание микробного загрязнения космических аппаратов и, потенциально, других планет.
В Хьюстонском университете изучили T. phoenicis, чтобы понять, что помогает ей выжить в суровых условиях. Результаты опубликованы в Microbiology Spectrum, рецензируемом научном журнале Американского общества микробиологии.
Исследование показало, что бактерия уклоняется от обнаружения, впадая в своеобразный анабиоз — состояние чрезвычайно низкой метаболической активности, при котором она перестает расти.
«Эти стерильные зоны становятся уникальной средой для адаптации и эволюции микроорганизмов. Полученные данные демонстрируют поразительную живучесть микробов на космических аппаратах, что влечет серьезнейший риск для планетарной защиты», — подчеркнул микробиолог Мадхэн Тирумалай.
Путь к открытию
T. phoenicis — это неспорообразующий штамм актинобактерий. Об этом конкретном штамме было известно немногое. Зато его родственница — вызывающая туберкулез Mycobacterium tuberculosis — изучена вдоль и поперек. Ученые знают о ее умении впадать в спячку в случае нехватки питательных веществ.
Состояние покоя — ключевая стратегия выживания актинобактерий, которая позволяет им противостоять антибиотикам и оставаться неактивными до улучшения условий.
Авторы исследования знали, что еще одного родственного микроба, Micrococcus luteus, можно вернуть к жизни из состояния покоя с помощью фактора реанимации — распространенного белка, содержащегося в актинобактериях. Поскольку M. luteus и T. phoenicis генетически очень схожи, белок решили проверить на находке из чистых помещений.
Когда добавили белок, клетки T. phoenicis «проснулись», что подтвердило способность бактерии «притворяться мертвой», чтобы пережить голодание и, возможно, противостоять суровым условиям в чистых помещениях для космических аппаратов, рассказал профессор Уильям Уиджер.
Что дальше?
Помимо сборочных цехов космических аппаратов, спящие актинобактерии могут скрываться и в других стерильных средах, таких как больницы, фармацевтические лаборатории и предприятия по переработке пищевых продуктов.
«Я думаю, что другие отрасли упускают из виду, что эти бактерии могут уклоняться от обнаружения в чистых помещениях, впадая в спячку. Мы не знаем, могут ли они приносить вред — может, и нет — но было бы неплохо знать, есть они там или нет», — отметил Уиджер.
Выводы исследователей также полезны для улучшению контроля над патогенными бактериями, такими как возбудитель туберкулеза. Если получится предотвратить спячку микробов — их будет легче уничтожить с помощью антибиотиков или методов стерилизации.
«Если мы сможем найти способ предотвратить переход бактерий в латентное состояние, возможно, антибиотики смогут убить их до того, как они впадут в спячку», — заключил профессор.
На космической станции «Тяньгун» открыли новый вид бактерий
Ученые предупредили о риске заражения Луны устойчивыми микробами
Подписывайтесь и читайте «Науку» в Telegram